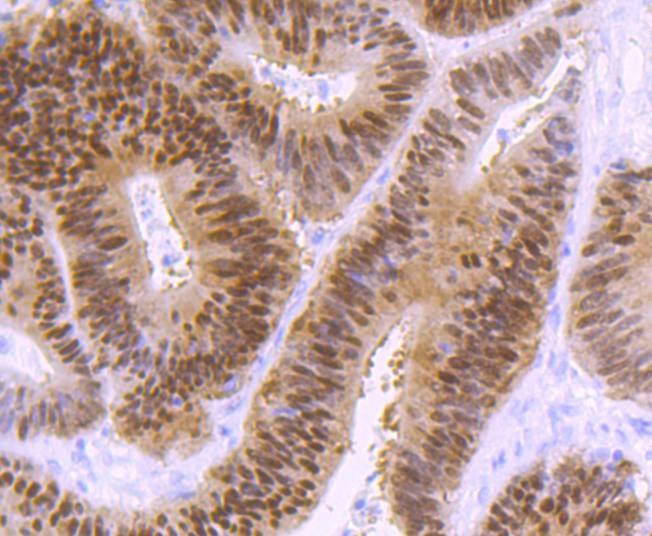

购物车
 您的购物车当前为空
您的购物车当前为空
Anti-CDX2 Antibody (1N738) 是一种 Rabbit 抗体,靶向 CDX2。Anti-CDX2 Antibody (1N738) 可用于 FCM,ICC/IF,IHC,WB。
别名 Homeobox protein CDX-2, Homeobox protein CDX 2, CDX-3, CDX3, CDX2_HUMAN, CDX2, CDX 3, CDX 2, Caudal-type homeobox protein 2, caudal type homeobox transcription factor 2, Caudal type homeobox protein 2, caudal type homeobox 2, caudal type homeo box transcription factor 2, Caudal type homeo box 2
Anti-CDX2 Antibody (1N738) 是一种 Rabbit 抗体,靶向 CDX2。Anti-CDX2 Antibody (1N738) 可用于 FCM,ICC/IF,IHC,WB。
| 规格 | 价格 | 库存 | 数量 |
|---|---|---|---|
| 50 μL | ¥ 1,495 | 5日内发货 | |
| 100 μL | ¥ 2,495 | 5日内发货 |
TargetMol的所有产品仅用作科学研究或药证申报,不能被用于人体,我们不向个人提供产品和服务。请您遵守承诺用途,不得违反法律法规规定用于任何其他用途。
| 产品描述 | Anti-CDX2 Antibody (1N738) is a Rabbit antibody targeting CDX2. Anti-CDX2 Antibody (1N738) can be used in FCM,ICC/IF,IHC,WB. |
| 别名 | Homeobox protein CDX-2, Homeobox protein CDX 2, CDX-3, CDX3, CDX2_HUMAN, CDX2, CDX 3, CDX 2, Caudal-type homeobox protein 2, caudal type homeobox transcription factor 2, Caudal type homeobox protein 2, caudal type homeobox 2, caudal type homeo box transcription factor 2, Caudal type homeo box 2 |
| Ig Type | IgG |
| 克隆号 | 1N738 |
| 反应种属 | Human,Rat,Rabbit |
| 验证活性 | 1. Western blot analysis of CDX2 on AGS cells lysates using anti-CDX2 antibody at 1/1,000 dilution. 2. Immunohistochemical analysis of paraffin-embedded human colon cancer tissue using anti-CDX2 antibody. Counter stained with hematoxylin. 3. Immunohistochemical analysis of paraffin-embedded rat large intestine tissue using anti-CDX2 antibody. Counter stained with hematoxylin. 4. ICC staining CDX2 in LOVO cells (red). The nuclear counter stain is DAPI (blue). Cells were fixed in paraformaldehyde, permeabilised with 0.25% Triton X100/PBS. 5. ICC staining CDX2 in AGS cells (red). The nuclear counter stain is DAPI (blue). Cells were fixed in paraformaldehyde, permeabilised with 0.25% Triton X100/PBS. 6. Flow cytometric analysis of Hela cells with CDX2 antibody at 1/50 dilution (red) compared with an unlabelled control (cells without incubation with primary antibody; black). Alexa Fluor 488-conjugated goat anti rabbit IgG was used as the secondary antibody. |
| 应用 | FCMICC/IFIHCWB |
| 推荐剂量 | WB: 1:1000-2000; IHC: 1:50-200; ICC/IF: 1:50-200; FCM: 1:50-100 |
| 抗体种类 | Monoclonal |
| 宿主来源 | Rabbit |
| 构建方式 | Recombinant Antibody |
| 纯化方式 | ProA affinity purified |
| 性状 | Liquid |
| 缓冲液 | 1*TBS (pH7.4), 1%BSA, 40%Glycerol. Preservative: 0.05% Sodium Azide. |
| 研究背景 | The members of the murine Cdx family (Cdx1, Cdx2, and Cdx4) are members of the caudal-type homeobox family of genes, which are homologues of the Drosophila 'caudal' gene required for anterior-posterior regional identity. The intestine-specific transcription factors Cdx1 and Cdx2 are candidate genes for directing intestinal development, differentiation, proliferation and maintenance of the intestinal phenotype. The relative expression of Cdx1 to Cdx2 protein may be important in the anterior to posterior patterning of the intestinal epithelium and in defining patterns of proliferation and differentiation along the crypt-villus axis. Cdx1 and Cdx2 are expressed in the small intestine and colon of fetus and adult. A decrease in human Cdx1 and/or Cdx2 expression is associated with colorectal tumorigenesis. Both Cdx1 and Cdx2 genes must be expressed to reduce tumorigenic potential, to increase sensitivity to apoptosis, and to reduce cell migration, suggesting that the two genes control the normal phenotype by independent pathways. |
| 偶联 | Unconjugated |
| 免疫原 | Recombinant Protein |
| Uniprot ID |
| 分子量 | Theoretical: 34 kDa. |
| 储存方式 | Store at -20°C or -80°C for 12 months. Avoid repeated freeze-thaw cycles. |
| 运输方式 | Shipping with blue ice. |